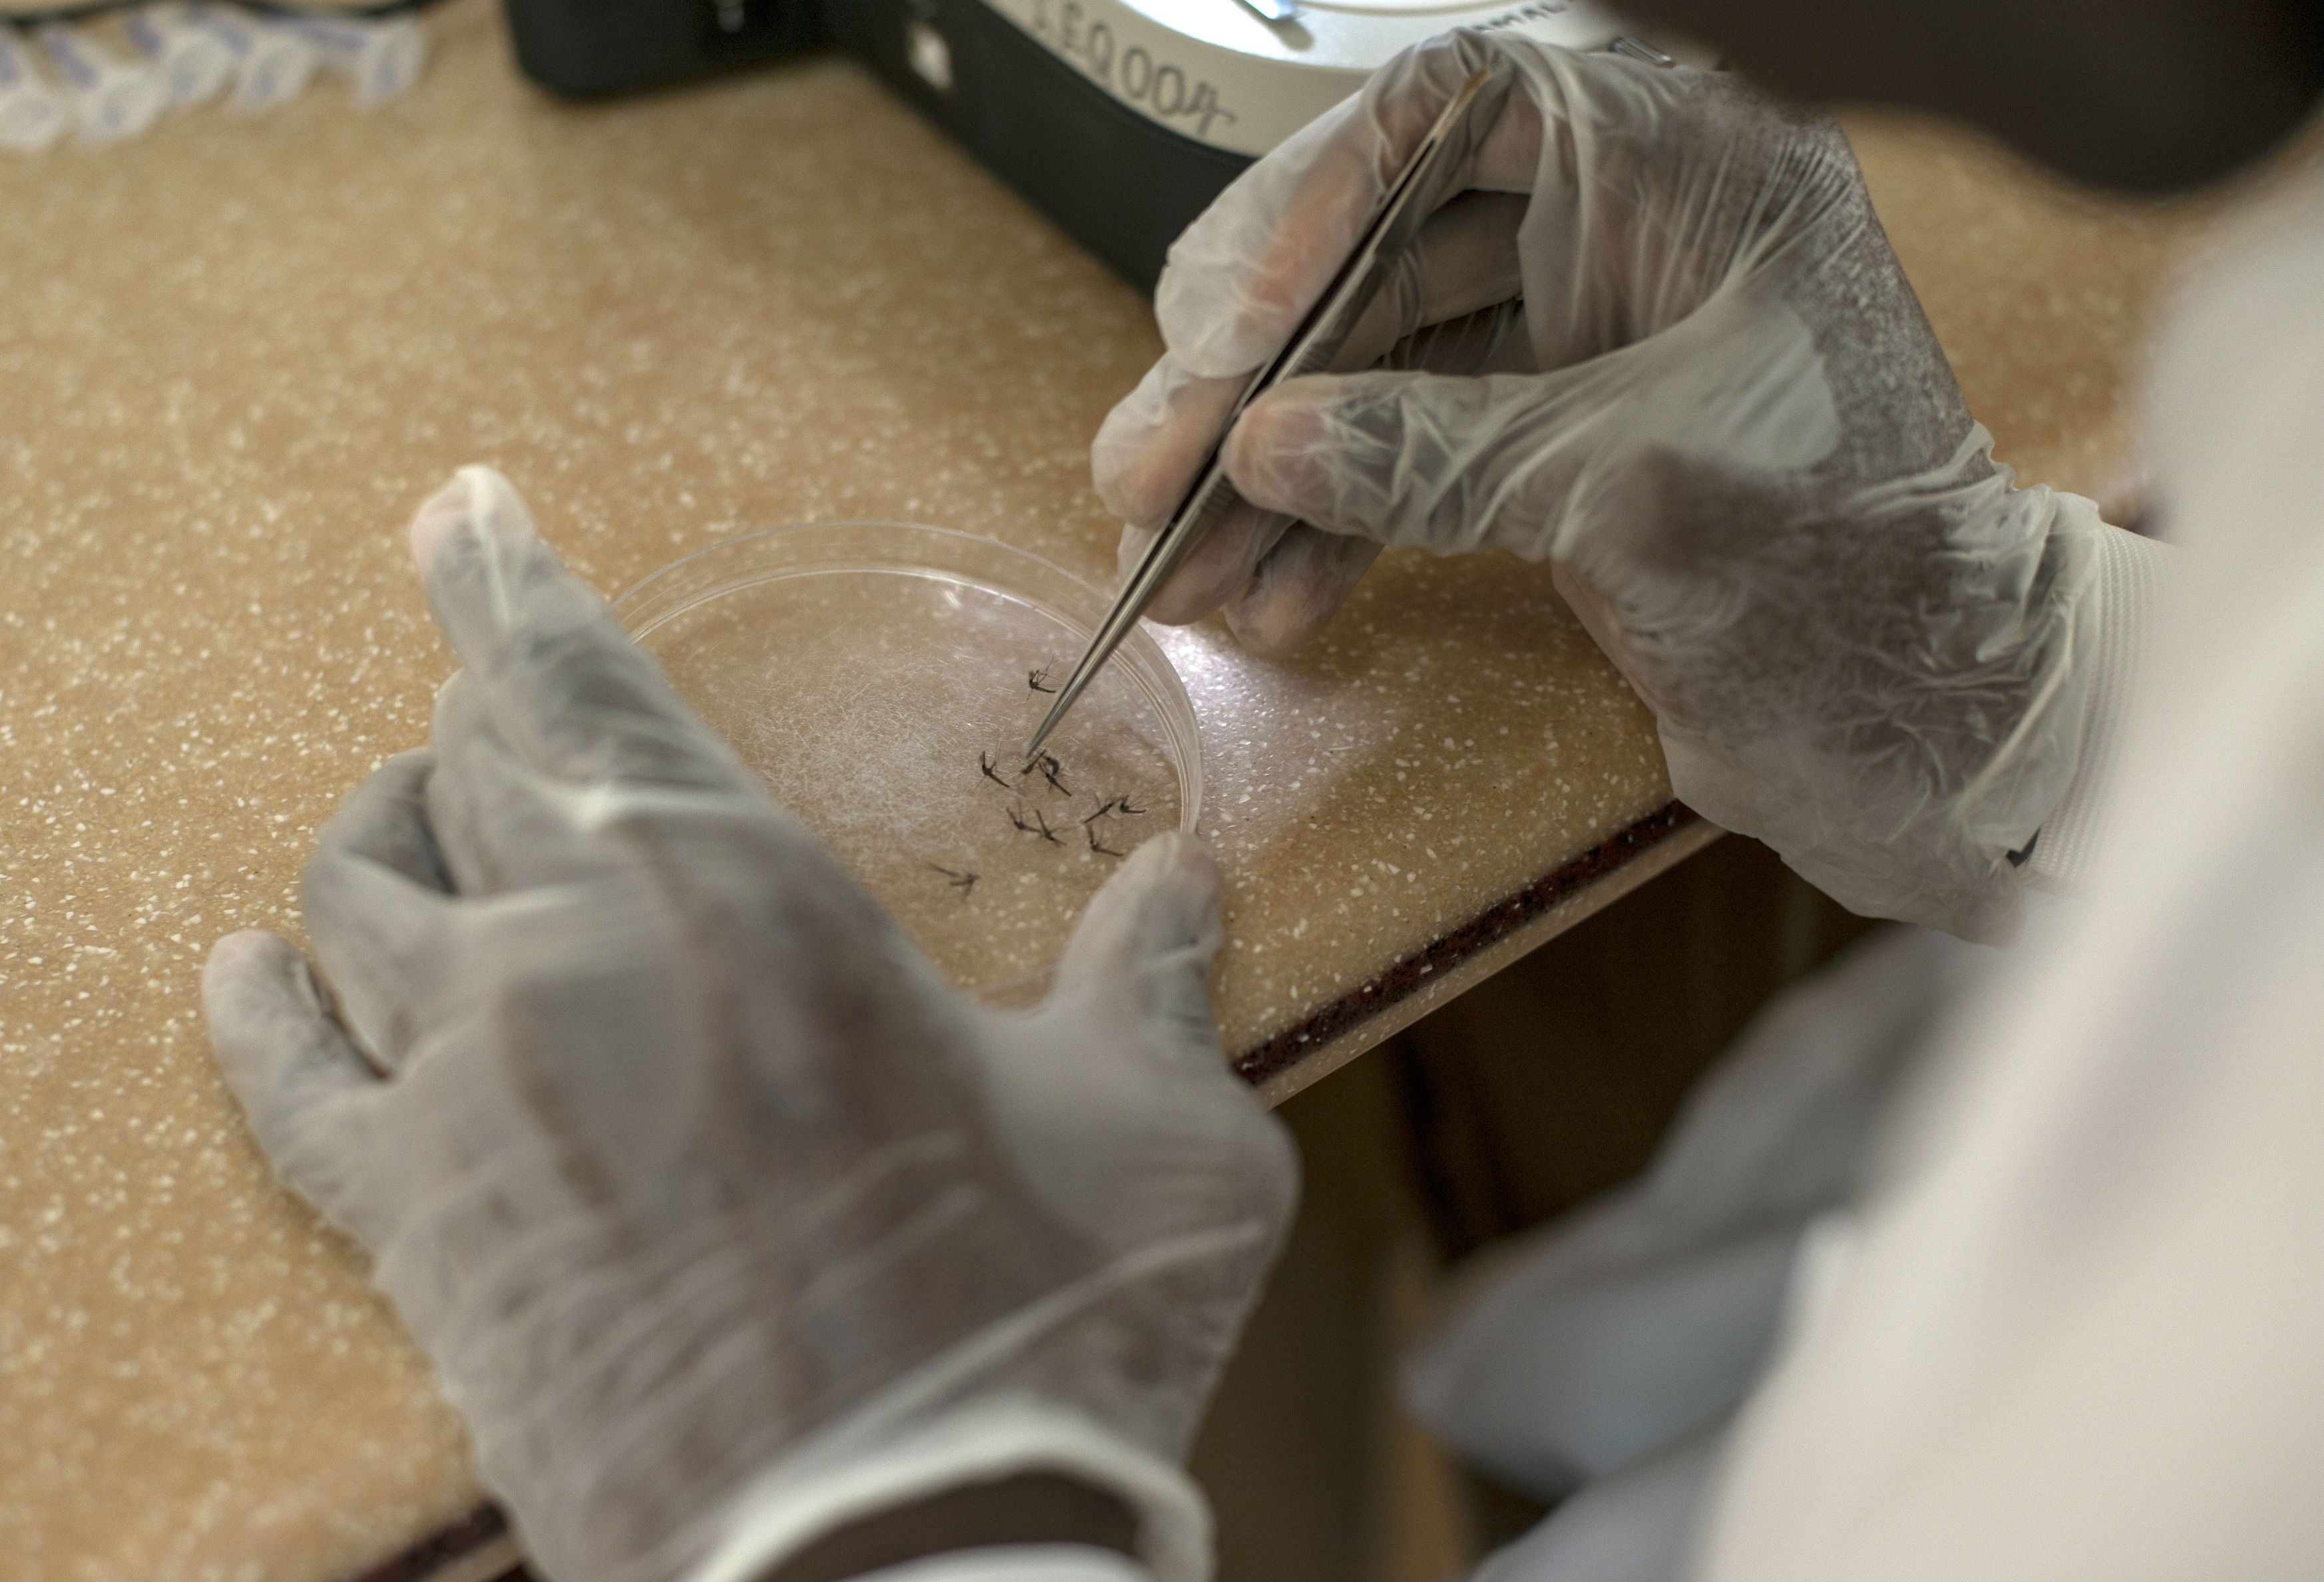
Malaria

Más de Alerta
Cebolla cabezona blanca
$ 2.031,45
-0,51%
Precio por kilo
Tomate chonto
$ 2.606,54
-32,86%
Precio por kilo
Papa pastusa
$ 1.595,43
-1,07%
Precio por kilo
Pechuga de pollo
$ 15.042,52
-0,25%
Precio por kilo
Cogote de carne de res
$ 22.896,60
+1,32%
Precio por kilo